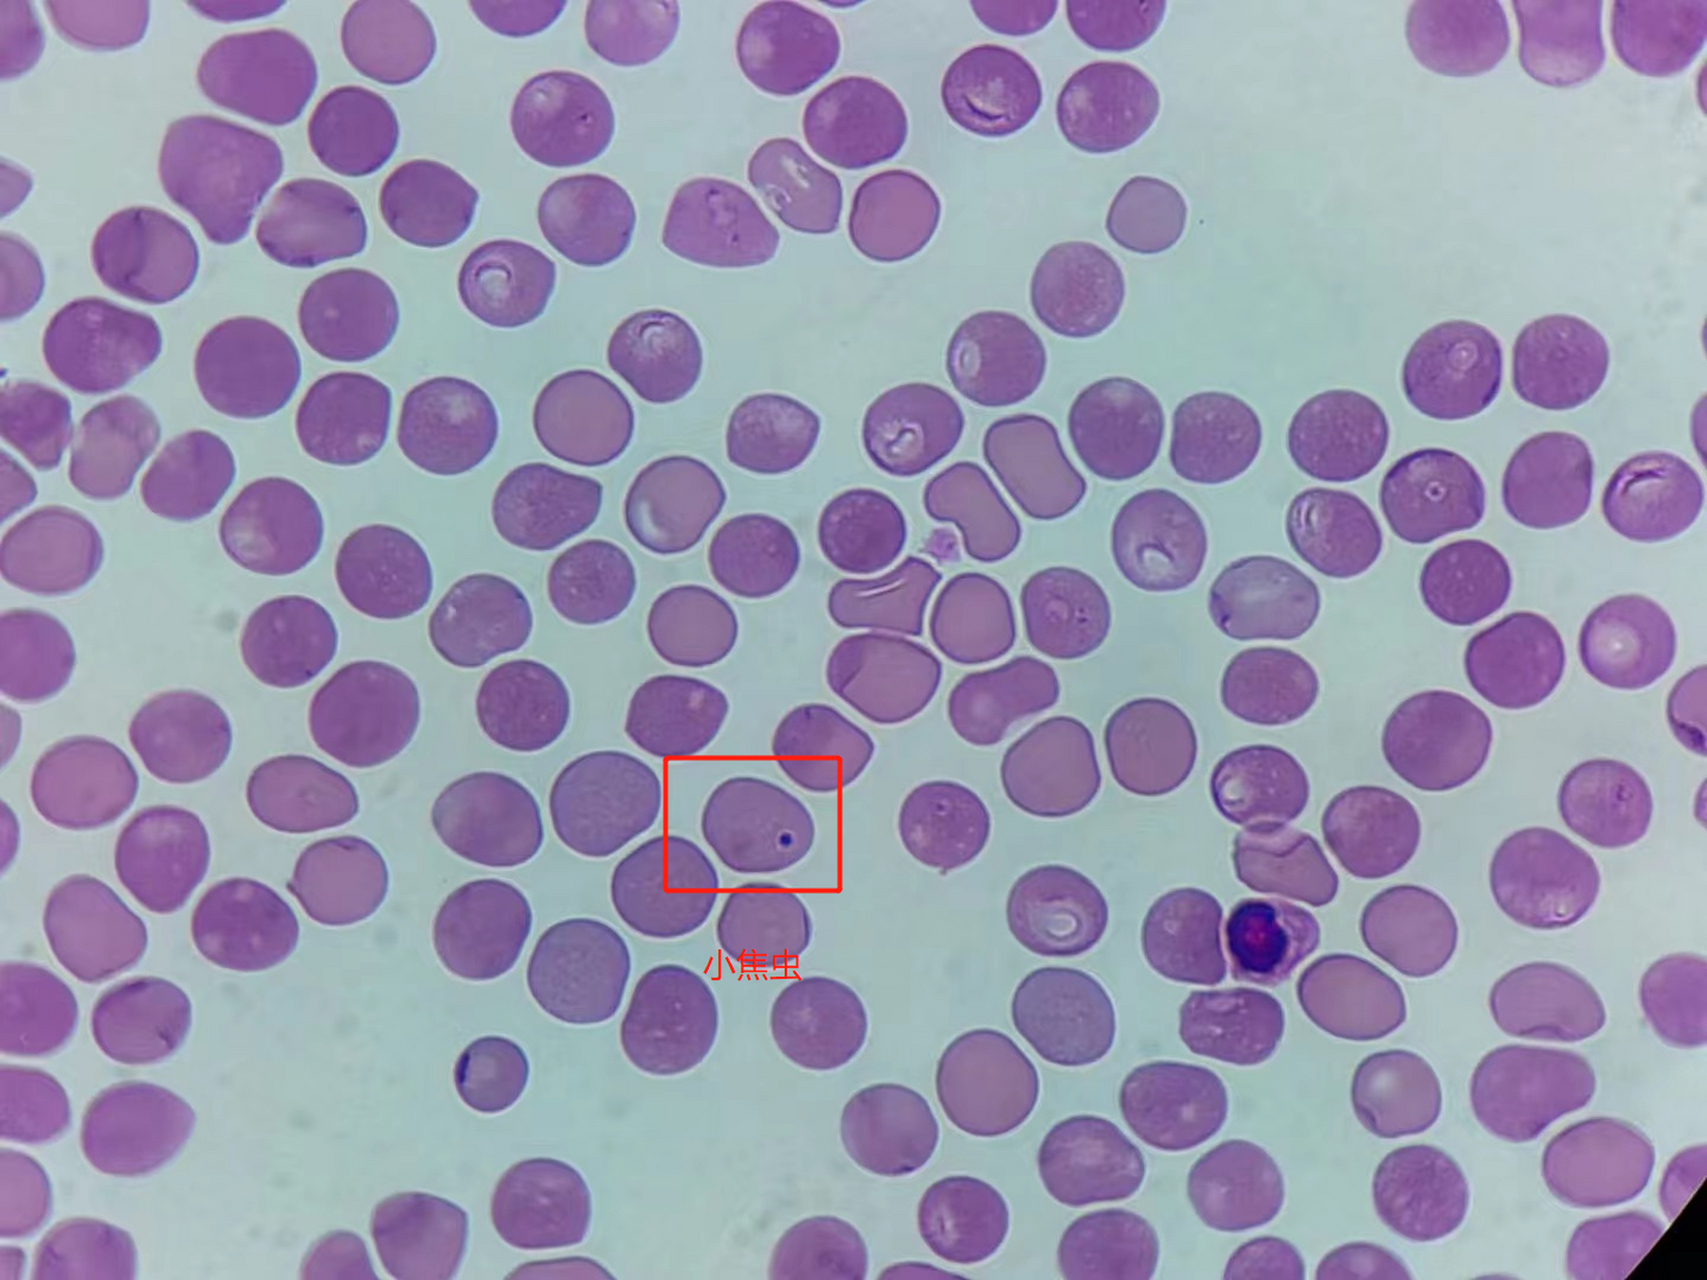
多例巴贝斯虫的诊断治疗体会(一) 博主是宠物医生,有血虫醌(阿托伐坤)

血虫醌

马师皇血虫醌阿托伐治疗贝斯虫焦虫病狗狗贫血嗜睡尿血猫
图片尺寸400x400
血虫阿托伐醌狗狗宠物小焦虫巴贝斯虫病焦虫猫狗通用营养膏
图片尺寸1080x1173
家中养狗警惕这种吸血虫
图片尺寸2048x1536
factory supply high quality resina draconis extract
图片尺寸1000x1349
感谢爱学习的我以前不知道怎么治疗现在把这个爷爷皮肤
图片尺寸1080x1440
有谁知道这个药叫什么
图片尺寸700x933
多例巴贝斯虫的诊断治疗体会(一) 博主是宠物医生,有血虫醌(阿托伐坤)
图片尺寸1707x1280
szechwan lovage rhizome extract 8:1
图片尺寸734x768
很实用,卫生部公布的保健食品的中药名单,既是食品又
图片尺寸1024x709
血虫醌阿托伐醌血虫病犬巴贝斯焦虫狗狗血液原虫大小焦虫贫血尿血 5kg
图片尺寸790x924
black nightshade extract 10:1 morel extract night
图片尺寸1000x999
血虫醌阿托伐醌宠物狗狗犬巴贝斯感染焦虫病血虫病贫血尿黄疸血虫醌15
图片尺寸800x800
high purity cas 12008-21-8 lab6 powder price
图片尺寸1122x720
oimg 血虫醌阿托伐醌宠物狗犬小焦虫病巴贝斯体内驱虫贫血黄疸无力
图片尺寸790x1240
产品展示_湖南世东医药有限公司
图片尺寸886x1004
2017 shandong moriko biotech co.,ltd cpoyright
图片尺寸800x600
lovage extract 10:1 tlc relieve pain, activate
图片尺寸460x332
血虫醌阿托伐醌治疗犬血虫巴贝斯虫焦虫病狗狗贫血嗜睡尿血【图片
图片尺寸990x963
血虫醌闲置最新日期有需要问我喔~_焦虫病_医疗健康_医疗药品
图片尺寸900x1200
阿托伐醌(血虫醌) - 上海固康生物科技有限公司
图片尺寸500x666